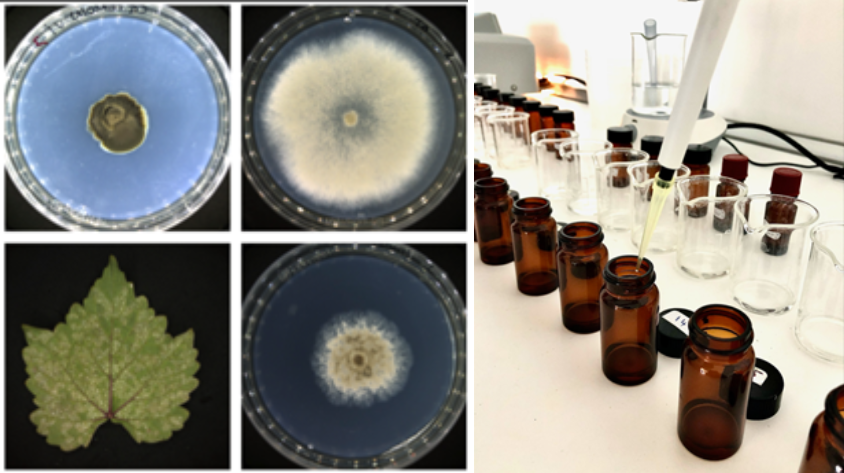

| Porteur du projet : | ChestNut |
| Labellisé le : | 06/2025 |
| Financeurs : | Région Auvergne-Rhône-Alpes (France 2030 régionalisé) |
ChestNut développe VeggieCareNext, une solution de biocontrôle fondée sur la valorisation de co-produits agricoles pour lutter contre les maladies fongiques en maraîchage. Labellisé par Innov’Alliance en juin 2025, le projet s’inscrit dans une dynamique de développement de biosolutions durables au service de la transition agroécologique.
Contexte :
Face à la réduction progressive des pesticides chimiques, les filières agricoles doivent accélérer le développement d’alternatives efficaces et durables. Les réglementations françaises et européennes encouragent cette évolution vers des pratiques plus respectueuses de l’environnement.
Dans ce contexte, les biosolutions apparaissent comme une voie stratégique. Parallèlement, la valorisation des co-produits agricoles ouvre de nouvelles perspectives en matière d’économie circulaire, en transformant des biomasses peu exploitées en ressources à forte valeur ajoutée.
Objectifs du projet
VeggieCareNext vise à développer des solutions de biocontrôle à partir de co-produits agricoles pour lutter contre les principales maladies fongiques des cultures maraîchères.
Le projet repose sur la valorisation de biomasses végétales telles que les sarments, pailles, bois ou encore peaux d’oignons. L’objectif est d’identifier, extraire et purifier des molécules actives d’origine végétale aux propriétés antifongiques.
Ces solutions ciblent notamment des pathogènes majeurs comme le mildiou, la fusariose ou le botrytis, pour lesquels les alternatives actuelles restent limitées. À terme, VeggieCareNext ambitionne de proposer des solutions capables de réduire l’usage des intrants chimiques tout en maintenant la performance des cultures.
Au-delà de l’innovation technique, le projet contribue à plusieurs enjeux structurants : valorisation des déchets agricoles, développement de nouvelles filières de valorisation et soutien à une agriculture plus résiliente.
Accompagnement Innov’Alliance :
ChestNut a sollicité Innov’Alliance dans le cadre de la labellisation du projet pour une demande de financement France 2030 régionalisé auprès de la Région Auvergne-Rhône-Alpes.
La labellisation, obtenue en juin 2025, a permis d’apporter un regard externe sur le projet et de consolider la cohérence technique du dossier. Elle constitue un appui pour structurer la démarche et renforcer la crédibilité du projet dans ses demandes de financement.
Vous avez un projet d’innovation ?
Bénéficiez de l’accompagnement d’Innov’Alliance et de notre procédure de labellisation de projet pour challenger votre dossier et maximiser vos chances d’obtenir un financement.
Contactez-nous dès maintenant :sandrine.lopis-presle@pole-innovalliance.com
